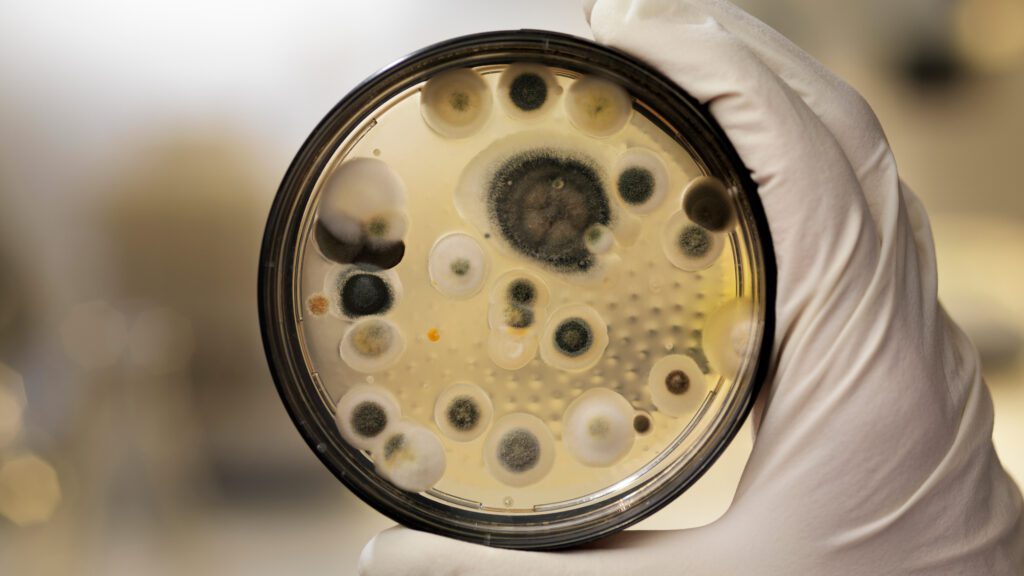
BG

Why do you need healthy air?
Healthy air is an essential part of a healthy home. Even more importantly, healthy air is essential to a healthy body. Mold is something we think about on surfaces or hidden in a wall somewhere. Few of us ever really think about mold in the air we breathe.
Mold
We breathe in mold spores and fragments every day, indoors and outdoors. Usually these exposures do not present a health risk. However, health problems may result when people are exposed to large amounts of mold, particularly indoors. Mold in the air can cause a host of health issues from something as minor as light seasonal allergies to severe immune response concerns.
Who should test their air quality?
We believe everyone should know the quality of the air they breath. We especially recommend and Indoor Air Quality Test for the following: 1. Older homes 2. People with low immune function such as the elderly and children 3. People who already show sensitivities toward common types of mold spores 4. Homes with a history of leaks or flooding 5. Homes with poor drainage around the structure If you are considering purchasing a new home in East New York or just have concerns about your current one, we can put your mind at ease with our Indoor Air Quality Testing.
What we inspect?
An Indoor Air Quality Test will test for the types of mold spores in the air. Some of these are harmless to most people. However, there are types mold that can cause very serious health concerns for many. This is why an Indoor Air Quality Test is so important. Our test is designed to test for a wide range of mold spores in your air. The results of your Indoor Air Quality Test will give a detailed breakdown of the types of mold found in your air, the concentration levels, and the health risks posed to your and your family.

